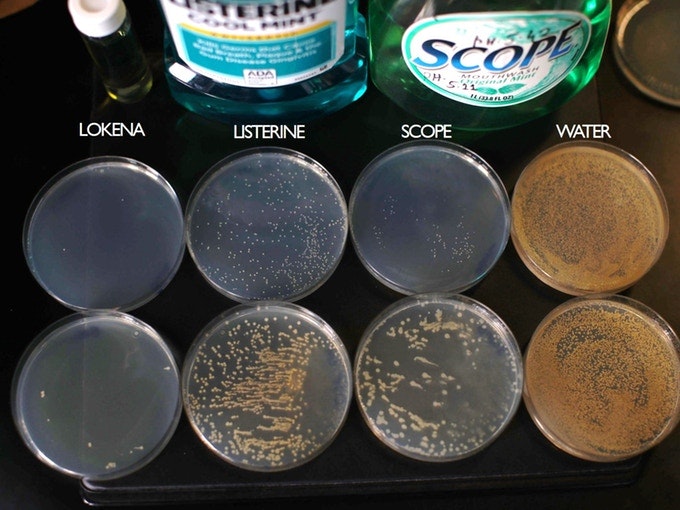
Lokena gallery image

Lokena
Natural Oral Care That Kills 1,000x More Germs
0 followers
Natural Oral Care That Kills 1,000x More Germs
0 followers
Most natural mouthwashes leave germs. Lots of them. But Lokena is different. Lokena's all-natural mouthwash and toothpaste obliterates germs — up to 1,000x more of them — than other natural brands. And...it's even more effective than Listerine.